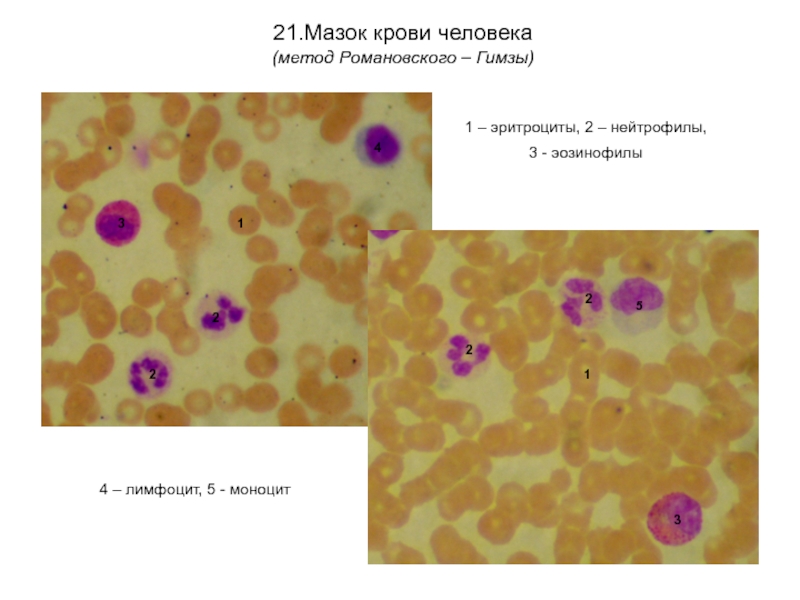

Разделы презентаций
- Разное
- Английский язык
- Астрономия
- Алгебра
- Биология
- География
- Геометрия
- Детские презентации
- Информатика
- История
- Литература
- Математика
- Медицина
- Менеджмент
- Музыка
- МХК
- Немецкий язык
- ОБЖ
- Обществознание
- Окружающий мир
- Педагогика
- Русский язык
- Технология
- Физика
- Философия
- Химия
- Шаблоны, картинки для презентаций
- Экология
- Экономика
- Юриспруденция
Министерство здравоохранения и социального развития РФ ГОУ ВПО Ижевская
Содержание
- 1. Министерство здравоохранения и социального развития РФ ГОУ ВПО Ижевская
- 2. УДД 611-018(076.5) ББК 28.706я73Авторы:И.В. Титова, Г.В. Шумихина,
- 3. Уважаемые
- 4. Общая гистология (учение о тканях)
- 5. Слайд 5
- 6. Слайд 6
- 7. Слайд 7
- 8. Слайд 8
- 9. Слайд 9
- 10. Слайд 10
- 11. Слайд 11
- 12. Слайд 12
- 13. Слайд 13
- 14. Слайд 14
- 15. Слайд 15
- 16. Слайд 16
- 17. Слайд 17
- 18. Слайд 18
- 19. Слайд 19
- 20. Слайд 20
- 21. Слайд 21
- 22. Слайд 22
- 23. Слайд 23
- 24. Слайд 24
- 25. Слайд 25
- 26. Слайд 26
- 27. Слайд 27
- 28. 24.Сперматозоиды человека (гематоксилин – эозин)
- 29. Частная гистология (органология)
- 30. Сердечно-сосудистая система
- 31. Сердечно-сосудистая система
- 32. Сердечно-сосудистая система
- 33. Сердечно-сосудистая система
- 34. Сердечно-сосудистая система
- 35. Иммунная система
- 36. Иммунная система
- 37. Иммунная система
- 38. Иммунная система
- 39. Нервная система
- 40. Нервная система
- 41. Нервная система
- 42. Нервная система
- 43. Нервная система
- 44. Нервная система
- 45. Органы чувств
- 46. Органы чувств
- 47. Органы чувств
- 48. Органы чувств
- 49. Органы чувств
- 50. Эндокринная система
- 51. Эндокринная система
- 52. Эндокринная система
- 53. Эндокринная система
- 54. Эндокринная система
- 55. Мужская половая система
- 56. Мужская половая система
- 57. Мужская половая система
- 58. Женская половая система
- 59. Женская половая система
- 60. Женская половая система
- 61. Женская половая система
- 62. Эмбриология
- 63. Эмбриология
- 64. Пищеварительная система
- 65. Пищеварительная система
- 66. Пищеварительная система
- 67. Пищеварительная система
- 68. Пищеварительная система
- 69. Пищеварительная система
- 70. Пищеварительная система
- 71. Пищеварительная система
- 72. Пищеварительная система
- 73. Пищеварительная система
- 74. Пищеварительная система
- 75. Пищеварительная система
- 76. Пищеварительная система
- 77. Пищеварительная система
- 78. Пищеварительная система
- 79. Пищеварительная система
- 80. Пищеварительная система
- 81. Выделительная система
- 82. Выделительная система
- 83. Выделительная система
- 84. Выделительная система
- 85. Дыхательная система
- 86. Дыхательная система
- 87. Слайд 87
- 88. Кожа и ее производные
- 89. Кожа и ее производные
- 90. УДАЧИ!
- 91. Скачать презентанцию
УДД 611-018(076.5) ББК 28.706я73Авторы:И.В. Титова, Г.В. Шумихина, Т.Г. Глушкова Рецензенты:Д.м.н., профессор Л.С. Исакова,Д.б.н., профессор Л.И. РастегаеваЛ 125 Лабораторный практикум по гистологии: электронное учебное пособие / И.В. Титова, Г.В. Шумихина, Т.Г.
Слайды и текст этой презентации
Слайд 1 Министерство здравоохранения и социального развития РФ ГОУ ВПО «Ижевская государственная медицинская
академия»
Лабораторный практикум
по гистологии
(учебное пособие)
Ижевск - 2011
Слайд 2УДД 611-018(076.5)
ББК 28.706я73
Авторы:
И.В. Титова, Г.В. Шумихина, Т.Г. Глушкова
Рецензенты:
Д.м.н., профессор
Л.С. Исакова,
Д.б.н., профессор Л.И. Растегаева
Л 125 Лабораторный практикум по
гистологии: электронное учебное пособие / И.В. Титова, Г.В. Шумихина, Т.Г. Глушкова. – Ижевск, 2011Электронное учебное пособие подготовлено в соответствии с Примерной программой по дисциплине гистология, эмбриология и цитология (Москва, 2002), и перечнем основных микропрепаратов, рекомендуемых для изучения студентами.
Учебное пособие рекомендуется для самоконтроля при подготовке к итоговым занятиям и экзамену по гистологии и включает фотографии с микропрепаратов, изучаемых студентами на лабораторных занятиях.
Предназначено для самостоятельной аудиторной и внеаудиторной работы студентов лечебного и педиатрического факультетов
Слайд 3 Уважаемые студенты!
Диагностика микропрепаратов является необходимым элементом
врачебных знаний. Описание препаратов представляют врачу-клиницисту цитологические, патологоанатомические, гематологические лаборатории. Врач должен понять представленный медицинский документ и использовать его для постановки диагноза. Основы диагностики микропрепаратов закладываются в ходе изучения гистологии, эмбриологии и цитологии, где студент должен овладеть умением микроскопировать гистологические, гистохимические и эмбриологические препараты, идентифицировать органы, ткани, их клеточные и неклеточные структуры на микроскопическом уровне.Для анализа микропрепаратов удобно пользоваться следующими схемами.
Схема описания микропрепарата по общей гистологии:
Определите ткань или ткани на препарате, метод окраски. Дайте название препарата.
Укажите структуры, которые подтверждают ваш вывод о типе ткани.
Схема описания микропрепарата по частной гистологии:
Определите тип органа (паренхиматозный или полый), метод окраски.
Выделите специфические для данного органа структуры. Назовите орган.
Определите структурные компоненты и тканевой состав органа.
В данном пособии представлены фотографии микропрепаратов, которые изучаются на практических занятиях и предлагаются для диагностики на экзамене по гистологии. Большинство препаратов даны как на малом, так и на большом увеличении. Переключение слайдов осуществляется с помощью клавиш «space» или «enter». Название препарата, метод окраски и обозначения структур вызываются повторным нажатием клавиши для того, чтобы вы могли проверить свои знания.